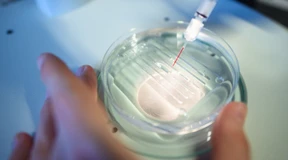
Keine Angst vor der Genschere

Die defensive Seite der Medaille
Beim Supercup in Hamburg wurde deutlich: Am Angriff dürfte das WM-Abenteuer der deutschen Basketball-Nationalmannschaft nicht scheitern. Aber kann das Team auch gut genug verteidigen?

Beim Supercup in Hamburg wurde deutlich: Am Angriff dürfte das WM-Abenteuer der deutschen Basketball-Nationalmannschaft nicht scheitern. Aber kann das Team auch gut genug verteidigen?

Rund zwei Wochen vor WM-Beginn begeistern Deutschlands Basketball-Profis vor heimischem Publikum. Zwar ist Gegner China kein Maßstab, dennoch machen Schröder und seine Teamkameraden Lust auf mehr.

Glücklich der Bundestrainer, der Dennis Schröder und Franz Wagner in seinen Reihen hat: Das deutsche Basketballteam spielt erfolgreich und lernt viel im WM-Test gegen Kanada. Anschließend verlängert Gordon Herbert seinen Vertrag.

Deutschlands Basketball-Nationalmannschaft gewinnt auch das zweite Spiel der WM-Vorbereitung. Gegen Kanada ist in Berlin eine starke Teamleistung zu sehen.
Es ist höchste Zeit, dass die Bundesregierung die ideologischen Scheuklappen bei der grünen Gentechnik ablegt. Denn die Wissenschaft spricht eine deutliche Sprache.

Laut Präsident Abdelmajid Tebboune wäre ein Eingreifen im Nachbarland eine Bedrohung für Algerien. Im Falle einer Intervention würde „die gesamte Sahelzone in Flammen aufgehen“.

In Kanada gilt der „Online News Act“. Er besagt, dass Onlinekonzerne für Medieninhalte zahlen müssen. Meta hat darauf die kanadische Presse ausgesperrt, Google will folgen – eine Herausforderung der Demokratie.

Hasst Taylor Swift Kanada? Diese Frage stellten sich Fans in den vergangenen Monaten immer wieder – die Sängerin gab nämlich Konzerttermine für die halbe Welt bekannt, nur nicht für Kanada. Sogar der Premierminister schaltete sich ein.

„Nach wichtigen und schwierigen Unterhaltungen haben wir entschieden, uns zu trennen“, teilen Trudeau und seine Ehefrau Sophie auf Instagram mit. Das Paar hat drei gemeinsame Kinder.

Die australischen Fußballerinnen erscheinen menschlich, sympathisch und kommen nicht arrogant daher. Schon gilt es als schick und aufgeklärt, den Matildas die Daumen zu drücken.

Der Weltmeister von 2011 präsentiert sich bei der WM in Australien und Neuseeland als Titelkandidat. Auch gegen Spanien zeigen die Japanerinnen ihre Klasse. Für Kanada ist das Turnier derweil beendet.

In vielen westlichen Ländern ist Chinas Image so schlecht wie noch nie. Positiv wird das Land vor allem in Lateinamerika und Afrika gesehen. Doch auch dort verschlechtert sich die Meinung über Peking.

Zum achten Mal kommen kleinwüchsige Athleten aus aller Welt bei den World Dwarf Games zusammen. Viele können sich erst hier unter fairen Bedingungen mit anderen messen – müssen dafür aber selbst zahlen.

Spaniens Fußballerinnen siegen 5:0 gegen Sambia, Japan setzt sich 2:0 gegen Costa Rica durch. Damit stehen die ersten beiden Achtelfinalisten dieser Weltmeisterschaft fest. Und auch Kanada darf erstmals jubeln.

Auf der griechischen Ferieninsel Rhodos wüten heftige Brände. Zehntausende Menschen fliehen vor den Flammen. Auch auf den griechischen Inseln Euböa und Korfu sind Brände ausgebrochen.

Die frühere Nationalspielerin Inka Grings bejubelt als Trainerin der Schweiz einen Auftaktsieg. Mitfavorit Kanada kommt nicht über ein torloses Remis hinaus. Spanien gibt sich gegen Costa Rica keine Blöße.

Ein See in Kanada wird zum „Golden Spike“ des Anthropozäns. Er archiviert auch, dass die Zivilisationskrise für die indigene Bevölkerung schon viel früher begann. Ein Gastbeitrag.

Die baltischen Staaten haben sich von Russland weitgehend abgekoppelt. Doch militärisch brauchen sie Schutz – von Kanada, Polen und Deutschland.

Vorsicht mit dem Daumen-Emoji: Ein Landwirt aus Kanada hatte damit auf ein Vertragsangebot per Textnachricht reagiert. Ein Gericht entschied nun, er sei damit einen Vertrag eingegangen.

Kanadische Fans warten bislang vergeblich auf eine Konzertankündigung von Taylor Swift. Nun nimmt sich der Premierminister der Sache an.

Spitzensportler klagen seit Jahren über Missbrauch und Fehlverhalten – doch in Kanada wird die Aufklärung von Verbänden gezielt unterminiert. Politiker wollen sich dezent aus der Affäre ziehen.

Waldbrände sind keine Seltenheit mehr. In der Bekämpfung spielen Löschflugzeuge eine wichtige Rolle. Manchmal sind sie die einzige Lösung. Welche gibt es und was können sie?

Die anhaltenden Waldbrände in Kanada sorgen bereits zum wiederholten Mal für schlechte Luftqualität in den USA. Die Luftqualitätswarnungen in Washington lagen am Donnerstag im roten Bereich.

Seit Mitte Mai registrieren Forscher dünne Rauchschichten über Deutschland. Nun gaben sie bekannt, dass er von den riesigen Waldbränden in Kanada stammt. Der Rauch beeinflusst die Atmosphäre und das Klima hierzulande.

Die Rauchwolke infolge der schweren Waldbrände in Kanada hat inzwischen Westeuropa erreicht. In den nächsten Tagen wird sie weiter nach Osten ziehen und auch Deutschland erreichen. Laut Deutschem Wetterdienst werde der Rauch jedoch in Höhenlagen bleiben.

Die Waldbrände in Kanada halten weiter an. An der spanischen Westküste sorgen Rauchpartikel für glutrote Sonnenuntergänge und trübe Luft.

Der durch die anhaltenden Waldbrände in Kanada entstandene Rauch ist mittlerweile auch in Europa angekommen – und verdunkelte jetzt den Himmel über Portugal.

Die kanadische Zeichnerin Kate Beaton hat fünfzehn Jahre nach eigenen Erlebnissen in den Ölförder-Camps von Alberta eine Comic-Sozialreportage gemacht, die den Sexismus in der Arbeitswelt dokumentiert.

Nach der Implosion des Tauchboots und dem tragischen Tod der fünf Insassen leiten die kanadischen Behörden Untersuchungen ein. Ermittler sollen auf Neufundland Zeugen befragen.

Vorbild Kanada und Australien: Bald gelten neue Regeln für die Einreise in den deutschen Arbeitsmarkt. Nun will die Koalition ihr Gesetz durch den Bundestag bringen. Darauf hat sie sich verständigt.

Diese Woche soll der Bundestag das Gesetz beschließen, das die Einwanderung von Fachkräften regelt. FDP-Vize Johannes Vogel wehrt sich gegen CDU-Kritik daran: Missbrauch sei „ausgeschlossen“.

Die Zeit ist knapp: Bei einem Tauchgang zur Titanic ist ein U-Boot mit fünf Menschen an Bord verschollen, der Sauerstoff reicht nur für 96 Stunden. Die Küstenwachen der USA und Kanadas sind mit Schiffen und Flugzeugen im Einsatz.

Jung und innovativ sind sie beim Formel-1-Rennstall Red Bull, aber auch extrem konservativ. Der Triumph von Max Verstappen in Kanada war schon der 100. Sieg für das Team. Was ist das Geheimnis des Erfolgs?

Red-Bull-Pilot Max Verstappen erringt in Kanada seinen 41. Sieg und zieht mit Ayrton Senna gleich. Die internationalen Medien sind begeistert von der Konstanz des Niederländers.

Der sechste Saisonsieg in dieser Formel-1-Saison, der vierte nacheinander, ist der 41. Erfolg in Max Verstappens Karriere. Damit liegt er mit 25 Jahren schon gleichauf mit dem legendären Ayrton Senna.

Nico Hülkenberg düpiert im Dauerregen in Montreal die Konkurrenz und landet im Qualifying auf Rang zwei. Dann erhält der Deutsche eine Strafe. Die Pole Position geht an Max Verstappen